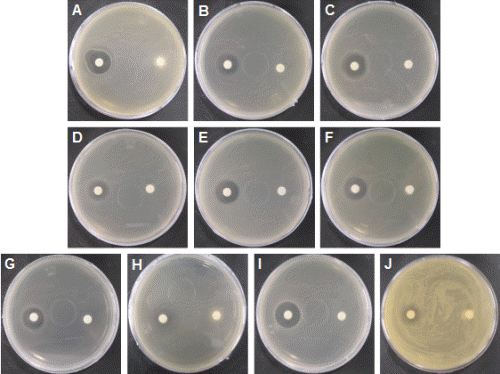
http://static.apub.kr/journalsite/sites/kshs/2014-032-05/N0130320516/images/PIC3EF3.gif

서 언
우리나라에서 재배되는 박과채소는 수박, 참외, 호박 등 10여 종에 불과하지만, 박과 식물은 그 종류가 118속 825종으로 매우 다양하며, cucurbitacin, charantin, saponin 등의 기능성 성분을 함유하고 있어 신소득원으로 활용가능성이 높은 작목이 많이 있다. 수세미오이는 관상용으로 사용하거나 과실 내부의 그물 섬유를 주방용 세척기구 및 유류의 오일 여과기로, 어린 과실은 미용제나 건강 보조용으로 사용해 왔다. 최근에는, 수세미오이의 수액이 해소나 천식에 뛰어난 효능이 있는 것으로 밝혀지면서 그 수요가 점차 증가하고 있는 추세이다.
수세미오이에 관한 국내・외 연구를 살펴보면, 온실과 노지조건에서 생육시기별 수액의 무기성분과 물리적 특성을 분석한 결과, 수액의 주요성분은 K, Ca, Mg으로 K의 함량이 가장 많았고, 온실에서 채취한 수액이 전체적으로 무기성분 함량이 높았으며 수액 채취시기에 따라서는 Ca을 제외하고 유의차가 없었다(Park et al., 1996). 또한 수세미오이의 종자, 식물체, 과즙과 수액으로부터 휘발성분, 탄화수소, 유기산, 비휘발성 지방산을 추출 분리한 연구가 보고되었다(Chang et al., 1991). 한편, 수세미오이의 종자와 뿌리털 추출물에 의한 흑색종 세포의 생장 억제효과(Poma et al., 1997), 수세미오이 종자의 영양적 가치 평가(Olaofea et al., 2008), 잎과 종자의 phytochemical과 항균특성 평가(Oyetayo et al., 2007) 등 식물체 부위별 의학 또는 의약분야의 적용가능성 모색이 이루어지고 있으며 수세미 배양세포로부터 분리한 bryonolic acid의 항알레르기 활성에 관한 연구(Tabatas et al., 1993; Tanaka et al., 1991)도 보고된 바 있다.
활성산소는 사람에게 많은 질병을 일으키는 원인으로 활성산소를 억제해 질병을 예방하거나 치료하는데, 활성산소를 억제하는 항산화제로는 superoxide dismutase, catalase, glutathione reductase, phenol계 화합물, ascorbic acid, carotenoid 등이 있다(Shin et al., 2008). 대부분 자연계에 존재하는 식물은 자외선과 외부 자극으로부터 자신을 보호하기 위하여 polyphenol계의 항산화물질을 함유하고 있으며(Kim et al., 2003; Wang et al., 1996), 천연식물을 이용하면 부작용이 없기 때문에 항산화에 대한 연구가 많이 진행되고 있다(Han et al., 2007; Kwon et al., 2008).
항균활성 분석에 사용한 Candida albicans는 효모균 중에서 약 85-90%의 감염을 일으키고, 인체에 면역력이 저하되면 기회성 감염을 유발하며(Chun et al., 2004; Kim et al., 2007), 정상조직 피부에 약 20% 정도 존재한다. 또한 여성의 질 내벽을 감염시키는 경우가 대다수이며 질염 중 약 20-25% 정도를 차지하고 있다(Kang et al., 2003). 한편, 비듬생성의 주 원인균으로 알려진 Malassezia furfur는 지루 부위에 상존하는 정상 균총의 46% 정도를 차지하며, 기후, 땀, 음식 등의 환경적인 요인과 스트레스 등의 생리적인 요인에 의해 Malassezia furfur가 모낭 내에서 과다하게 증식하여 74% 이상이 되면 비듬이 생기게 되고 83%를 넘을 경우 지루성 피부염으로 발병되게 된다(Lee and Lee, 2007).
수세미오이는 열매를 이용한 발효제품, 건강식품, 화장수, 비누 등으로 상품화되어 판매되고 있다. 또한, 수세미 오이의 줄기를 절단한 후 채취한 수액의 소비도 증가하고 있다. 특히 수세미오이의 수액은 기능성 성분을 함유하고 있고, 의료용 소재로의 활용 가능성이 높다고 일부에서는 주장하고 있으나 이에 대한 연구는 미흡한 실정이다.
따라서 본 실험은 재래종 수세미 오이의 수액을 채취하여 무기성분을 분석하고 부위별 항산화효소 활성과 항균 활성을 측정하여 수세미오이의 이용확대 방안을 검토하고자 하였다.
재료 및 방법
실험재료 및 재배방법
수세미오이(Luffa cylindrica Roem)는 국립농업유전자원센터에서 분양 받은 재래종 수세미오이(K051462)를 시험재료로 사용하였다. 수원 이목동 소재의 국립원예특작과학원에서 2009년 4월 12일 파종하여 시설하우스 안에 터널을 설치하고 5월 11일 50cm 간격으로 정식하였으며 10월 28일에 과실을 수확하였다. 수세미오이는 주지와 측지 2본을 재배하였으며, 정식 후 수확까지의 일평균 기온은 15.7-25.7°C 범위였고, 관수는 토양과 기후조건에 따라 점적호스로 공급하였다. 참조용으로 백다다기 오이를 함께 재배하여 비교분석하였다.
수액 채취 및 무기성분 분석
수세미오이 수액은 과실 수확 후 뿌리에서 가까운 지상부 50cm 위치의 줄기를 절단하여 비닐로 테이핑한 후 1.8L 용량의 플라스틱 수통에 채취하였다. 수액채취 일주일 전 관수를 실시한 후 10월 29일부터 11월 4일까지 5일 동안 채취하였다. 무기성분은 수세미오이 수액과 수액 침전물을 대상으로 N, P, K, Ca, Mg 등 다량원소 5성분과 Na, Fe, Cu, Zn, Mn 등 미량원소 5성분을 분석하였다. 수액은 채취한 날로부터 3일이 경과한 후 No.2 여과지로 여과하였다. 여과지에 남은 물질은 건조하여 침전물 분석에 사용하였고, 여과된 용액은 수액 분석에 이용하였다. N은 Kjeldahl 방법(Eastin, 1978)으로 자동질소분석장치(Kjeltec auto 1040 analyzer, Tecator, Sweden)로 측정하였고, P는 Vanadate법으로 UV/VIS spectrophotometer(UV-3150, Shimadzu, Japan)를 이용하여 측정하였으며 이외 양이온은 원자흡광광도계(AA6800F, Shimadzu, Japan)로 분석하였다.
항산화 효소
항산화 효소활성 분석은 Fig. 1에 나타난 바와 같이 수세미오이의 잎, 줄기, 뿌리, 꽃, 과육, 과피, 종자, 수액과 오이 과실 등 각 부위를 구분하여 채취한 후 동결 건조하여 항산화효소 분석에 사용하였다. 시료조제는 동결건조 시료 0.5g에 2mM ethylenediaminetetraacetic acid(EDTA), 1%(w/v) polyvinylpyrrolidone-40, 1mM phenylmethylsulfonyl fluoride가 첨가된 100mM potassium phosphate buffer(pH 7.5)에서 균질화하여 15,000g로 20분간 원심분리한 다음 상층액을 항산화효소 분석에 사용하였다. 단백질 정량은 bovine serum albumin을 표준물질로 사용하여 Bradford(1976) 방법에 따라 측정하였다.
|
|
|
Fig. 1. Activities of antioxidant enzymes in various plant parts of sponge gourd and cucumber fruit. Vertical bars denote standard errors of three replicates. |
Superoxide dismutase(SOD) 활성 검정은 SOD 분석 키트(Sigma, USA)를 사용하여 측정하였다. SOD의 활성을 nitroblue tetrazolium(NBT)의 환원을 저해하는 능력으로 간접 검정하는 키트다. 반응액은 0.1mM EDTA, 0.1mM Xanthine이 첨가된 50mM carbonic buffer(pH 10.2)로 하였으며, 0.025mM NBT의 환원 저해율을 흡광도 450nm에서 측정하였다. 각 시료에 대하여 3회 반복으로 하였다.
Catalase(CAT) 활성은 H2O2의 초기 분해율을 측정하는 Mishra et al.(1993)의 방법으로 검정하였다. 반응액은 50mM potassium phosphate buffer(pH 7.0)와 10mM H2O2로 하였다. CAT 활성은 반응액에 추출액을 가한 다음 240nm에 2분간의 흡광도 변화를 측정하였다(Chen and Asada, 1989).
Ascorbate peroxidase(APX) 활성은 Chen and Asada(1989) 방법에 따라 ascorbate의 산화 정도를 290nm에서 2분간의 흡광도 변화로 측정하였다. APX의 반응액은 0.5mM ascorbate와 0.2mM H2O2가 첨가된 100mM potassium phosphate buffer(pH 7.5)로 하였다.
항균 활성
수세미오이 수액의 식품유해균 10종에 대한 항균활성을 검정하였다. 사용한 균은 Staphylococcus aureus, Escherichia coli, Proteus mirabilis, Salmonella typhymurium, Bacillus subtilis, Micrococcus luteus, Enterococcus hirae, Vibrio parahaemdyticus, Staphylococcus epiderdimis, Propionibacterium acne였다. 배지는 tryptic soy agar를 사용하였으며 대조구로는 penicillin을 사용하였다.
병원성 진균에 대한 수세미오이의 부위별 항균활성 분석을 위해 Candida albicans와 Malassezia furfur 균을 사용하였다. Candida albicans는 LB broth와 agar(Difco, USA)를, Malassezia furfur는 YM broth와 agar(Difco, USA)를 배지로 사용하였다.
수세미오이 추출물의 항균활성은 agar diffusion test(Bauer et al., 1966)를 사용하여 측정하였다. 즉, 각 시험미생물에 적합한 배지에 107cfu・mL-1 농도로 시험미생물을 배양한 soft agar를 petri dish에 분주한 후 paper disc를 올려 놓고 disc당 수세미오이 추출물을 40µL씩 흡수시켰다. 37°C에서 배양하여 24시간 이내에 paper disc 주위에 저해환이 생성된 경우 항균활성이 양성인 것으로 판정하였으며, 저해환의 직경을 측정, 비교하였다.
결과 및 고찰
무기성분 분석
수세미오이 수액의 무기성분 분석 결과 K, Ca, P, Mg이 주요성분이었으며, K의 함량이 470mg・L-1로 가장 많은 것으로 나타났는데 이러한 경향은 Park et al.(1996)의 결과와 유사하였다(Table 1). Ca과 Mg의 함량은 오이의 약 2배와 1.7배로 높게 나타났으며, 특히 Ca 함량은 440mg・L-1로 고로쇠나무의 수액(153mg・L-1)뿐 아니라 모유(270mg・L-1)나 사골(240mg・L-1)(Chung et al., 1995)보다도 높은 것으로 나타났다. 수세미오이 수액의 탁도는 채취 시기나 재배 장소와 상관없이 증류수와 유사하며, 상온 저장에서도 색도, 탁도, 당도 등이 큰 변화 없이 안정적이므로(Na et al., 2009) 향후 음료로 제조가 가능하리라 판단된다.
수세미오이의 수액은 채취 후에 침전물이 생긴다. 수액 생산 및 판매 농가에서는 수액을 채취한 후 2-3일 간 방치하였다가 망에 침전물을 걸러 보관, 판매하고 있다. 수액 침전물이 생기는 원인을 구명하기 위하여 무기성분을 분석해 본 결과 침전물의 주요 성분은 P와 Ca으로 수액보다 그 함량이 각각 1,000배와 466배로 매우 높게 나타났다(Table 2). P 이온과 Ca 이온이 만나면 인산칼슘으로 화합되어 침전이 생기게 된다(Pardossi, 2011). 수액의 침전물은 P와 Ca 함량이 주성분으로서 수액에서 높은 함량을 가진 P와 Ca이 만나 불용성인 인산칼슘이 형성된 것으로 생각된다.
수세미오이 수액은 K, Ca, P, Mg의 다량원소가 매우 풍부할 뿐 아니라 Fe, Cu, Zn, Mn 등 미량원소도 고르게 검출되어 무기성분 공급 측면에서 매우 좋은 소재로 나타났다.
항산화효소 활성분석
수세미오이의 조직별 항산화효소 활성을 분석한 결과 APX의 활성은 잎, 꽃, 뿌리, 과육에서 3,126-2,933µmol H2O2 decomposed min-1・mg-1 protein으로 높게 나타났고, 과피와 종자에서는 2,708-2,698µmol, 수액에서는 2,366µmol이었으며, 줄기에서는 451µmol으로 가장 낮았다(Fig. 1).
CAT 활성은 꽃, 과육, 과피, 잎, 수액에서 207-180µmol H2O2 decomposed min-1・mg-1 protein으로 높게 나타났고, 종자는 165µmol이었으며, 줄기에서는 63µmol로 낮게 나타났다.
SOD 활성은 잎, 꽃, 뿌리, 과실조직에서는 42-34%였고 줄기에서 4%로 가장 낮게 나타났다. 전체적으로 APX 활성이 CAT와 SOD보다 높았고, 오이와 비교해 볼 때 APX는 높았고 CAT는 낮았으며 SOD는 비슷한 수준으로 나타났다. 식물체 부위별로 비교해 볼 때 수세미 수액의 항산화효소 활성은 줄기를 제외한 다른 부위 즉, 잎, 뿌리, 꽃, 과육, 과피, 종자가 비슷한 수준으로 높게 나타났다(Fig. 1). 수세미오이의 과실은 cinnamic acid 유도체와 flavonoid glycosides와 같은 페놀화합물을 함유하고 있어 항산화능이 높은 것으로 알려졌다(Ansari et al., 2005; Du et al., 2006). Du et al.(2006)은 과육부분에서 p-coumaric acid 등 8가지 항산화물질을 분리해 내고 이들 물질이 건물중의 1%를 차지한다고 하였으며 이러한 결과는 수세미오이의 섭취를 통하여 인체에 항산화물질을 공급할 수 있다는 것을 보여준다고 하였다. 본 실험에서 과육뿐 아니라 줄기를 제외한 식물체의 모든 부위와 수액에서 항산화효소 활성이 모두 높게 나타났으며 이는 인체에서 활성산소를 제거하는데 역할을 할 것으로 생각된다.
항균활성 분석
수세미오이 수액의 식품유해균 10종에 대한 항균활성을 조사한 결과(Fig. 2), Vibrio parahaemdyticus와 Propionibacterium acne에 대하여 미미한 활성을 보였지만 Staphylococus aureus, Escherichia coli 등 식품에 발생할 수 있는 다른 8종의 균에 대해서는 항균효과가 없었다. 수세미오이의 종자와 잎 추출물은 Escherichia. coli, Staphylococcus aureus, Salmonella typhi, Bacillus subtilis에 대해 항균활성을 나타냈고(Oyetayo et al., 2007), 과실의 에탄올 추출물은 그람 양성균과 음성균에 대해 항균활성이 보고되었다(Devi et al., 2009). 수세미오이의 수액은 채취 후 2년간은 실온에서 보관이 가능하나 본 연구결과 수액은 식품유해균을 억제하는 효과는 적은 것으로 나타났다.
수세미오이의 부위별 Malassezia furfur에 대한 항균활성 실험결과(Table 3), 수세미오이의 수액에서 18mm의 생육 저해환을 보여 가장 높은 항균활성을 보였다. 뿌리는 14mm, 잎과 과육은 12mm, 줄기, 과피, 종자는 11mm의 생육 저해환을 보이는 등 정도 차이는 있었지만 수세미오이 식물체와 수액 모두 Malassezia furfur에 대한 항균력을 가지고 있었다. 이것은 Lee and Lee(2007)가 구절초의 추출물을 대상으로 Malassezia furfur에 대한 항균활성을 조사한 결과 7mm의 생육 저해환을 보였다는 것과 비교해 볼 때 수세미오이 수액의 항균활성이 매우 높음을 알 수 있었다.
|
Fig. 3. Antimicrobial activities in various plant parts of sponge gourd against to skin pathogens. A, Malassezia furfur; B, Candida albicans. |
Candida albicans에 대해서는 수액에서 13mm의 생육저해환을 형성하여 항균활성이 가장 높았고 잎에서 그 다음으로 높게 나타났다. 생육 저해환은 줄기와 뿌리는 10mm, 과피는 9mm를 형성하였다. 이러한 경향은 Devi et al.(2009)의 수세미오이 과실 에탄올 추출물에 대한 항균활성 실험결과와 유사하였다. Malassezia furfur에 대해서는 식물체 부위별로 모두 향균활성을 보였으나 Candida albicans에 대해서는 꽃, 과육, 종자는 항균활성을 나타내지 않았다. 수세미오이 수액이 아토피 질환자의 화장수로도 사용되고 있는데 Candida albicans에 대한 항균력이 이러한 역할에 도움을 주는 것으로 생각되며 추후 이에 대한 심도 있는 연구가 필요할 것으로 보인다.
전체적으로 수세미오이의 항균활성은 비듬, 어루러기 등 곰팡이성 피부병 원인균인 Malassezia furfur에 대한 활성이 구강과 질에 감염을 일으키고 중증 아토피 피부염에서 가장 큰 알레르기 유발 물질인 Candida albicans에 대한 활성보다 높은 것으로 나타났다(Fig. 3). 식물체 부위별 항균활성은 수세미오이 수액의 항균활성이 잎, 과실 등의 다른 부위보다도 높게 나타나, 수세미오이의 수액을 이용하여 생활용품으로 제품화하면 산업적 가치가 매우 클 것으로 생각되었다.
농가에서는 수액과 과실뿐 아니라 건조한 줄기나 이의 추출물, 식물체를 활용한 차나 환도 상품으로 판매하고 있다. 활용 목적에 따라 본 연구결과를 바탕으로 항산화 활성이나 향균 활성이 높은 식물체 부위를 사용하면 수세미오이의 기능성 활용을 극대화할 수 있을 것으로 생각되며 추후 효과적인 추출방법에 대한 연구와 동물(인체)실험이 필요할 것으로 생각된다.